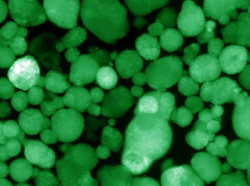
Crean las primeras c&eacute;lulas humanas trasplantables que producen insulina para tratar la diabetes tipo 1

Desarrollan un nuevo tratamiento que funciona en tumores sólidos de alto riesgo con menor toxicidad
Investigadores del Children`s Hospital of Philadelphia (CHOP), en Estados Unidos, han desarrollado un tratamiento que ha mostrado éxito en tumores sólidos de alto riesgo que no sólo supera la resistencia común a los medicamentos sino que tiene el potencial de provocar menos toxicidades que la mayoría de los tratamientos contra el cáncer, según publican en `Cancer Research`, la revista de la Asociación Estadounidense para la Investigación del Cáncer.